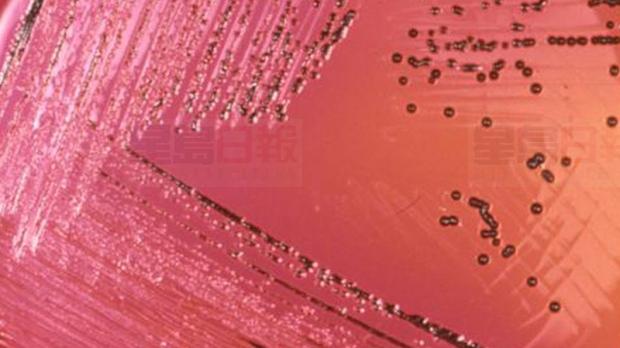

加拿大公共衛生局發出警告,全國六個省份爆發沙門氏菌疫情,包括卑詩省23宗、亞省10宗、沙省8宗、緬省與安省各10宗、魁省兩宗,暫時未查出爆發源頭,衛生局正配合各省衛生部門和加拿大食物檢查局調查。
衛生局表示,患者在2018年11月至2019年3月發病,其中18人要留院,兩人死亡,但未知死因是否與沙門氏菌有關,患者界乎1歲至87歲。
衛生局相信,仍有感染個案未作出報告。
感染沙門氏菌的病徵包括發燒、發冷、肚瀉、腹痛、頭痛、嘔吐等,感染病毒後約72小時發病;嬰兒、小童、長者、免疫力低的人最高風險。
(CTV圖片)
V06